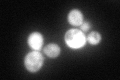
YHR104W
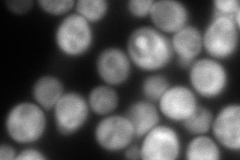
YHR104W
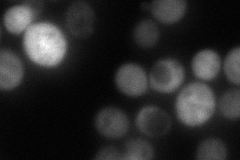
YHR104W
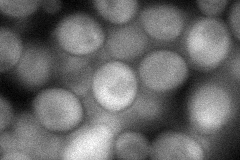
YHR104W
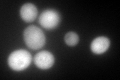
YHR104W
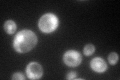
YHR104W

View description
Aldose reductase involved in methylglyoxal, d-xylose, arabinose, and galactose metabolism; stress induced (osmotic, ionic, oxidative, heat shock, starvation and heavy metals); regulated by the HOG pathway
Localization:
Intensity:
Fold change:
Significance:
-
C’ GFP library in SD
cytosol73.49 -
N' NOP1pr-GFP in SD

cytosol206.404 -
N' TEF2pr-mCherry in SD
cytosol259.539 -
N' NATIVEpr-GFP in SD
cytosol98.5774 -
N' TEF2pr-VC and Cyto-VN in SD
cytosol75.3323 -
C’ GFP library in SD+DTT
cytosol139.921.9Yes -
C’ GFP library in SD+H2O2

nucleusN/AN/ANo -
C’ GFP library in Starvation Media
nucleusN/AN/AYes -
C’ GFP library on the background of Pup2-DaMP

cytosol -
C’ GFP library on the background of CCT mutant

cytosol120.4061.63824Yes
